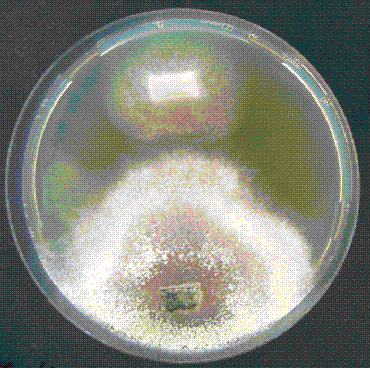

Projekte
Chemotropism in the fungus-fungus interaction
The defining feature of the fungal hypha is continued polarised tip growth which enables the otherwise immobile cells to spatially explore the environment in order to locate and exploit new substrates. This is driven by a range of sensory responses that determine the direction of growth of germ tubes and mature hyphae, a behaviour known as tropism. Chemotropism is a highly conserved form of tropism, occurs in response to a huge variety of chemical substances, and can be divided into positive chemotropism, i.e. attraction towards a compound source, and negative chemotropism, i.e. away from a compound source. Growing hyphae are continuously exposed to a variety of chemoattractant compounds including self-signals, for example to promote cell-cell fusion for colony network formation or mating, non-self signals, such as host-derived compounds that trigger mycoparasitism, or nutrient signals of other carbon and nitrogen sources available in the surrounding.

Different signaling pathways are implicated in the regulation of chemotropism, including a signaling network comprising G-protein coupled receptors (GPCRs), mitogen activated protein kinases (MAPKs), small GTPases and NADPH oxidases (NOX). Further important components related to chemoattractive directional tip growth are the Rho-family GTPases Rac1 and Cdc42, key regulators of eukaryotic cell polarity. Although the molecular tool box of these responses is highly conserved amongst eukaryotes, the pathway wiring underlying chemotropic responses in T. atroviride remain poorly understood. Especially concerning the nature of the host-derived signals and responsive pathway components that trigger activation of the mycoparasitic attack program. Therefore, this project aims on identifying the sensing and signaling components regulating mycoparasitism of T. atroviride with the intention to inform the development of novel biocontrol strategies.
Relevant publications: